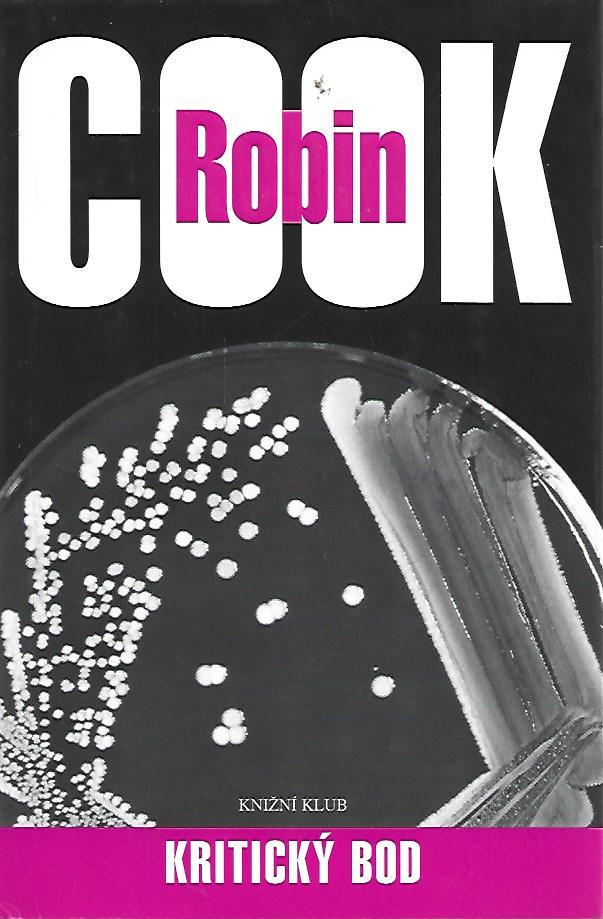

Světová beletrie
Informace ke knihám:
Zobrazit vše,
Skrýt vše
Předchozí
1
2
3
4
5
6
7
8
9
10
11
12
13
14
15
16
17
18
19
20
21
22
23
24
25
26
27
28
29
30
31
32
33
34
35
36
37
38
39
40
41
42
43
44
45
46
47
48
49
50
51
52
53
54
55
56
57
58
59
60
61
62
63
64
65
66
67
68
69
70
71
72
73
74
75
76
77
78
79
80
81
82
83
84
85
86
87
88
89
90
91
92
93
94
95
96
97
98
99
100
101
102
103
104
105
106
107
108
109
110
111
112
113
114
115
116
117
118
Další
| Název ⇩ | Autor | Cena | ||||||||||||
|---|---|---|---|---|---|---|---|---|---|---|---|---|---|---|

|
Krásná Hedvika | NIŽNÁNSKÝ Jožo | 150 Kč | Koupit | ||||||||||

|
Krásná intrikánka (Versailleské romány VI.) | SCHREIBER Hermann | 150 Kč | Koupit | ||||||||||

|
Krásná loupežnice | REESOVÁ Celia | 140 Kč | Koupit | ||||||||||
| Krásná Niverňanka | DAUDET Alphonse | 110 Kč | Koupit | |||||||||||
|
||||||||||||||

|
Krásná sezona | ATKINSONOVÁ Patricia | 120 Kč | Koupit | ||||||||||

|
Krásná Sidonie | DAUDET Alphonse | 150 Kč | Koupit | ||||||||||

|
Krásné a tragické lásky v dějinách | CASTELOT André | 140 Kč | Koupit | ||||||||||

|
Krásné lži | UNGEROVÁ Lisa | 160 Kč | Koupit | ||||||||||

|
Krásné zlo | JAMES Rebecca | 160 Kč | Koupit | ||||||||||

|
Krásný Antonio | BRANCATI Vitaliano | 110 Kč | Koupit | ||||||||||

|
Kráter | PRESTON Douglas | 170 Kč | Koupit | ||||||||||

|
Kráter | PRESTON Douglas | 130 Kč | Koupit | ||||||||||

|
Krátká projížďka v nebeském kočáře | SAROYAN William | 120 Kč | Koupit | ||||||||||

|
Krátký druhý život Bree Tannerové | MEYEROVÁ Stephanie | 170 Kč | Koupit | ||||||||||

|
Krátký, leč divuplný život Oskara Wajda | DÍAZ Junot | 220 Kč | Koupit | ||||||||||

|
Kratochvilná vyprávění | BARHEBRAEUS A.G. | 90 Kč | Koupit | ||||||||||

|
Kratší než vzdech | PHILIPOVÁ Anne | 70 Kč | Koupit | ||||||||||

|
Kreatura | FARKAS Péter | 100 Kč | Koupit | ||||||||||

|
Krédo pro třetí tisíciletí | McCULLOUGHOVÁ Colleen | 140 Kč | Koupit | ||||||||||

|
Krejcarový román | BRECHT Bertolt | 140 Kč | Koupit | ||||||||||
| Krejcarový román/ Obchody pana Julia Caesara | BRECHT Bertolt | 300 Kč | Koupit | |||||||||||
|
||||||||||||||

|
Krejčí z Panamy | CARRÉ John le | 140 Kč | Koupit | ||||||||||

|
Kresby v prachu | KLEINOVÁ Zoë | 220 Kč | Koupit | ||||||||||

|
Křest ohněm | COYLE Harold | 160 Kč | Koupit | ||||||||||

|
Křesťané 1 : Vojákův plášť | GALLO Max | 130 Kč | Koupit | ||||||||||

|
Křesťané 2. : Křest krále | GALLO Max | 130 Kč | Koupit | ||||||||||

|
Kreutzerova sonáta | MOOROVÁ Margriet de | 80 Kč | Koupit | ||||||||||

|
Kreutzerova sonáta | TOLSTOJ Lev Nikolajevič | 150 Kč | Koupit | ||||||||||
| Kreutzerova sonata | TOLSTOJ Lev Nikolajevič | 120 Kč | Koupit | |||||||||||
|
||||||||||||||

|
Kreutzerova sonáta | TOLSTOJ Lev Nikolajevič | 120 Kč | Koupit | ||||||||||

|
Krev a spravedlnost | MOORE Pete | 150 Kč | Koupit | ||||||||||

|
Krev jednorožce | FINNEYOVÁ Patricia | 100 Kč | Koupit | ||||||||||

|
Krev královská | LEWIS Sinclair | 140 Kč | Koupit | ||||||||||

|
Krev královská | LEWIS Sinclair | 100 Kč | Koupit | ||||||||||

|
Krev květů | AMIRREZVANI Anita | 210 Kč | Koupit | ||||||||||

|
Krev mé krve | CARLISLE Helen Grace | 180 Kč | Koupit | ||||||||||

|
Krev mé krve | CARLISLE Helen Grace | 140 Kč | Koupit | ||||||||||

|
Krev mučedníků | BERTRAND Louis | 190 Kč | Koupit | ||||||||||

|
Krev se nezapře | DAVIES Robertson | 110 Kč | Koupit | ||||||||||

|
Krev se nezapře | DAVIES Robertson | 130 Kč | Koupit | ||||||||||

|
Krevní mafie | KONSALIK Heinz G. | 140 Kč | Koupit | ||||||||||

|
Kříďák | TUDOR C.J. | 280 Kč | Koupit | ||||||||||

|
Kříďák | TUDOR C.J. | 230 Kč | Koupit | ||||||||||

|
Křídla medůzy | NANCE John J. | 150 Kč | Koupit | ||||||||||

|
Křídla osudu | LANIGANOVÁ Catherine | 130 Kč | Koupit | ||||||||||

|
Křídla osudu | LANIGANOVÁ Catherine | 120 Kč | Koupit | ||||||||||

|
Křik Halidonu | LUDLUM Robert | 90 Kč | Koupit | ||||||||||

|
Křik Halidonu | LUDLUM Robert | 180 Kč | Koupit | ||||||||||

|
Kriminalistický cestopis | KISCH Egon Erwin | 550 Kč | Koupit | ||||||||||

|
Kriminálnice | SARRAZINOVÁ Albertine | 100 Kč | Koupit | ||||||||||

|
Kriminálník | VONNEGUT Kurt jr. | 140 Kč | Koupit | ||||||||||

|
Křišťálová lebka | SCOTTOVÁ Manda | 180 Kč | Koupit | ||||||||||

|
Křišťálový serail | KAMPHOEVENER Elsa Sophia von | 130 Kč | Koupit | ||||||||||

|
Kristián Wahnschaffe | WASSERMANN Jakob | 300 Kč | Koupit | ||||||||||
| Kristina | HOUGHTON Claude | 170 Kč | Koupit | |||||||||||
|
||||||||||||||

|
Kristina | HOUGHTON Claude | 180 Kč | Koupit | ||||||||||

|
Kristina Vavřincová | UNDSETOVÁ Sigrid | 330 Kč | Koupit | ||||||||||

|
Kristina Vavřincová I - III | UNDSETOVÁ Sigrid | 300 Kč | Koupit | ||||||||||

|
Kristina Vavřincová I - III | UNDSETOVÁ Sigrid | 360 Kč | Koupit | ||||||||||

|
Kristina Vavřincová I - III | UNDSETOVÁ Sigrid | 360 Kč | Koupit | ||||||||||

|
Kristina Vavřincová I.-II.: Věnec/ Paní | UNDSETOVÁ Sigrid | 300 Kč | Koupit | ||||||||||

|
Kristina Vavřincová: I. věnec/ II. Paní | UNDSETOVÁ Sigrid | 300 Kč | Koupit | ||||||||||

|
Kristus znovu ukřižovaný | KAZANTZAKIS Nikos | 160 Kč | Koupit | ||||||||||

|
Kristus znovu ukřižovaný | KAZANTZAKIS Nikos | 170 Kč | Koupit | ||||||||||

|
Kristus znovu ukřižovaný | KAZANTZAKIS Nikos | 140 Kč | Koupit | ||||||||||

|
Kritická hmota | MARTINI Steve | 150 Kč | Koupit | ||||||||||

|
Kritické články | DOSTOJEVSKÝ Fjodor Michajlovič | 170 Kč | Koupit | ||||||||||

|
Kritické články | DOSTOJEVSKIJ Fjodor Michajlovič | 170 Kč | Koupit | ||||||||||

|
Kritický bod | COOK Robin | 220 Kč | Koupit | ||||||||||

|
Kritický stav | SHOBIN David | 130 Kč | Koupit | ||||||||||

|
Kritický stav | STEARNOVÁ Martha | 120 Kč | Koupit | ||||||||||

|
Křižáci | SIENKIEWICZ Henryk | 220 Kč | Koupit | ||||||||||
| Křižáci 1 -4 | KOSSAKOVÁ Zofia | 300 Kč | Koupit | |||||||||||
|
||||||||||||||

|
Křižáci I., II. | SIENKIEWICZ Henryk | 300 Kč | Koupit | ||||||||||

|
Křižáci I., II. | SIENKIEWICZ Henryk | 400 Kč | Koupit | ||||||||||

|
Křižáci na západě | HEYM Stefan | 180 Kč | Koupit | ||||||||||

|
Křižáci na západě | HEYM Stefan | 150 Kč | Koupit | ||||||||||

|
Křižácké zlato | GIBBINS David | 190 Kč | Koupit | ||||||||||

|
Křižákův hrob | CRONIN Archibal Joseph | 120 Kč | Koupit | ||||||||||

|
Krize | McCLURE Ken | 130 Kč | Koupit | ||||||||||

|
Krize v Candylandu | POTTKEROVÁ Jan | 120 Kč | Koupit | ||||||||||

|
Křižník Artemis | FORESTER Cecil Scott | 120 Kč | Koupit | ||||||||||

|
Křižník Artemis | FORESTER Cecil Scott | 180 Kč | Koupit | ||||||||||

|
Křižník Aurora | JUNGA J. | 110 Kč | Koupit | ||||||||||

|
Křížová cesta 1,2,3 | TOLSTOJ Alexej Nikolajevič | 180 Kč | Koupit | ||||||||||

|
Křížová cesta 1-3 | TOLSTOJ Alexej Nikolajevič | 230 Kč | Koupit | ||||||||||

|
Křížová cesta 1-3 | TOLSTOJ Alexej Nikolajevič | 320 Kč | Koupit | ||||||||||
| Křižovatky | YOUNG Wm. Paul | 190 Kč | Koupit | |||||||||||
|
||||||||||||||

|
Krkavčí láska | WAWERZINEK Peter | 290 Kč | Koupit | ||||||||||

|
Krokodil | DOSTOJEVSKIJ Fjodor Michajlovič | 240 Kč | Koupit | ||||||||||

|
Kroky ke slunci | ADDISON Corban | 190 Kč | Koupit | ||||||||||
| Kronika kláštera Narovčatského | FEDIN Konstantin | 80 Kč | Koupit | |||||||||||
|
||||||||||||||

|
Kronika ohlášené smrti | MÁRQUEZ Gabriel García | 140 Kč | Koupit | ||||||||||

|
Kronika Pickwickova klubu | DICKENS Charles | 400 Kč | Koupit | ||||||||||

|
Kronika Pickwickova klubu | DICKENS Charles | 260 Kč | Koupit | ||||||||||

|
Kronika Pickwickova klubu | DICKENS Charles | 500 Kč | Koupit | ||||||||||

|
Kronika Pickwickova klubu | DICKENS Charles | 350 Kč | Koupit | ||||||||||

|
Kronika Pickwikova klubu | DICKENS Charles | 280 Kč | Koupit | ||||||||||
| Kronika prokletých zaklínačů 1.: Nádherné bytosti | GARCIOVÁ Kami, STOHLOVÁ Margaret | 270 Kč | Koupit | |||||||||||
|
||||||||||||||

|
Kronika rodu Medicehjů: Kmotr z Provance | SCHRÖDER Rainer M. | 300 Kč | Koupit | ||||||||||